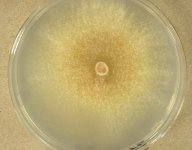

Search Details
| UAMH Number: | 3101 |
|---|---|
| Species Name: | Scytalidium cuboideum |
| Type: | Geotrichum microsporum |
| Synonyms: | Alysidium cubodeum / Alysidium cuboideum / Arthrographis cuboidea / Briosia microspora / Coremiella cuboidea / Geotrichum cuboideum / Geotrichum microsporum / Oospora cuboidea |
| Taxonomy: | FUNGI Ascomycota, Leotiomycetes, Helotiales, Helotiaceae |
| Strain History: | G. Smith -> IMI 94091 -> UAMH |
| Substrate: | rotten timber | Location: | SOUTH AFRICA Johannesburg (GEO: -26.204,28.047) |
| Isolator: | G. Smith |
| Isolation Date: | 1955 |
| Date Received: | 1969-03-19 |
| Characters: | MOLECULAR SYSTEMATICS classification in Leotiomycetes with affinity to Xylogone - Kang HJ, Sigler L, Lee J, Gibas CFC, Yun SH, Lee Y, Mycologia 102:1167-1184, 2010 // PIGMENT pink - (Click for publications citing UAMH 3101) |
| Compounds: | |
| Cross Reference: | CBS 241.62 // IMI 94091 // LSHB BB-386 // MUCL 11626 // NCMH 352 // TRL 2370 // UAMH 4040 |
| Collections: | Living Strains; Dried Herbarium Material |
| Pathogenic Potential: | Human: yes | Animal: no | Plant: yes |
| Biosafety Risk Group: | RG2 (check the PHAC ePATHogen Risk Group Database for updates) |
| Regulatory Requirements: | Canadian requesters must provide PHAC Pathogen and Toxin License Number (see: https://www.canada.ca/en/public-health/services/laboratory-biosafety-biosecurity/licensing-program.html) prior to shipment. International requesters must provide all legally required importation documentation prior to shipment. Plant pathogenicity status may be verified by using the USDA Agricultural Research Service (ARS) Fungal Database |
| MycoBank ID: | 515403 |
| Sequences: | >UAMH03101_GQ290132_RNApol2 CTTTCTCATNGNNGTCGTACTAATACACCTATTGGTCGTGATGGAAAGATTGCTAAACCCCGTCAATTGCATAATACTCACTGGGGTTTGGTCTGTCCAGCTGAAACTCCGGAAGGTCAAGCTTGTGGCCTGGTCAAGAACCTCGCTCTTATGTGTTATGTTACCGTTGGTACTCCTAGCGATCCTATCGTTGAATTCATGATTCAGCGAAATATGGAGGTTCTAGAAGAATATGATCCGGTTAGATCGCCGAATATGACAAAGGTCTTTGTCAACGGTGTTTGGGTAGGAGTCCATCGTGAGCCTGCTCATCTTGTGAGTACCGTGCAACATCTTCGACGTTCTCATTTGATCTCTCACGAAGTCTCTTTAATCAGAGATATTCGTGACCGAGAATTCAAGATCTTCACGGATGCTGGCAGAGTTTGCAGGCCGCTATTCGTCATCGACAATGACGTTGACAGCGCGAACAAGGGTAACCTAGTACTCAATAAAGACCATATTAGGAGACTCGAGGAAGATCAGACTTTGCCAGCAAATATGGACATGGAGCAAAGAAGGGAAGCAGGCTATTTCGGTTTCCAAGGGTTGATTAATGAGGGTGTGGTCGAATATGTTGATGCCGAAGAAGAAGAGACAATTATGATTGTGATGACTCCGGAAGATTTGGACATTTCTCGACAACTTCAAGCTGGATATCAAATNNNNNNNNNNNNNNNNNNNNNNNNNNNNNNNNNNNNNNNNNNNNNNNNNNNNNNNNNNNNNNNNNNNNNNNNNNNNNNNNNNNNNNNNNNNNNNNNNNNNGGAGTATTCCTCACCAACTATGATCAGCGTATGGATACCATGGCCAATATTTTGTACTATCCTCAGAAGCCACTTGCTACTACACGTTCTATGGAATTCTTGAAGTTCAGAGAGCTTCCAGCAGGACAGAATGCAATTGTCGCTATCGCTTGTTACTCTGGTTATAACCNAGAAGATTCCGTTATTATGAACCAGAGTAGTATTGATCGTGGTCTCTTCCGAAGTCTCTTCTACAGAGCATACACCGACCAAGAGAAACGAATTGGTATGAACGTTGTTGAACAGTTCGAGAAACCGTTCAGGGCAGATACCTTGAAGCTGAAACATGGTACATACGACAAACTCGACGACGATGGAATCATCGCTCCAGGTGTCCGTGTCTCTGGAGAAGATATCATCATTGGGAAGACAGCGCCTATTGCCCCAGATTCGGAAGAACTTGGTCAAAGAACGAAGGCTCATGTCAAGCGTGATGCTTCCACACCCCTCAGGAGTACTGAGAACGGTATTGTTGATCAGGTTCTTATTACTACCAATGCAGAGGGTCTCCGATTTGTCAAGGTTCGTATGCGAACTACAAAGATCCCACAGATTGGTGATAAATTTGCTTCACGTCACGGACAGAAAGGTACTATTGGTATTACTTATCGACAGGAAGATATGCCGTTCACTAGACAGGGTATTGTGCCGGATTTGATCATCAATCCTCATGCCATTCCATCTCGTATGACAATTGCTCACTTGATTGAGTGTCAATTGAGCAAGGTTTCCACTCTTCGTGGGCTCGAGGGTGATGNTACACCTTTCACTGAAGTGACAGTCGACTCGGTTTCAAAGCTTCTCCGCGCTCACGGTTACCAATCTCGTGGGTTCGAGATCATGTACCACGGCCATACTGGGCGGAAGCTTAAGGCACAAGTCTTCTTCGGTCCTACGTACTACCAGAGATTGCGTCACATGGTCGACG >UAMH03101_GQ280409_SSU ANNTGTCTGTCTCAGATTAGCCATGCATGTCTAAGTATAAGCAATCTATACTGTGAAACTGCGAATGGCTCATTAAATCAGTTATCGTTTATTTGATAGTACCTTACTACTTGGATAACCGTGGTAATTCTAGAGCTAATACATGCTAAAAACCTCGACTTCGGAAGGGGTGTATTTATTAGATAAAAAACCAATGCCCTTCGGGGCTCCTTGGTGATTCATAATAACTTAACGAATCGCATGGCCTTGTGCCGGCGATGGTTCATTCAAATTTCTGCCCTATCAACTTTCGATGGTAGGATAGTGGCCTACCATGGTTTCAACGGGTAACGGGGAATTAGGGTTCTATTCCGGAGAGCGAGCCTGAGACACGGCTAGCACATCCAAGGAAGGCAGCAGGCGCGCAAATTACCCAATCCCGACACGGGGAGGTAGTGACAATAAATACTGATACAGGACTCTTTTGGGTCTTGTAATTGGAATGAGTACAATTTAAATCCCTTAACGAGGAACAATTGGAGGGCAAGTCTGGTGCCAGCAGCCGCGGTAATTCCAGCTCCAATAGCGTATATTAAAGTTGTTGCAGTTAAAAAGCTCGTAGTTGAACCTTGGGCCTGGCTGGCCGGTCCGCCTCACCGCGTGCACTGGTCCGGCCGGGCCTTTCCTTCTGGGGAGCCGCATGCCCTTCACTGGGTGTGTCGGGGAACCAGGACTTTTACTTTGAAAAAATTAGAGTGTTCAAAGCAGGCCTATGCTCGAATACATTAGCATGGAATAATAGAATAGGACGTGTGGTTCTATTTTGTTGGTTTCTAGGACCGCCGTAATGATCAATAGGGATAGTCGGGGGCATCAGTATTCAATTGTCAGAGGTGAAATTCTTGGATTTATTGAAGACTAACTACTGCGAAAGCATTTGCCAAGGATGTTTTCATTAATCAGTGAACGAAAGTTAGGGGATCGAAGACGATCAGATACCGTCGTAGTCTTAACCATAAACTATGCCGACTAGGGATCGGGCGATGTTACTTTTTTGACTCGCTCGGCACCTTACGAGAAATCAAAGTCTTTGGGTTCTGGGGGGAGTATGGTCGCAAGGCTGAAACTTAAAGAAATTGACGGAAGGGCACCACAATGGAGTGGAGCCTGCGGCTTAATTTGACTCAACACGGGGAAACTCACCAGGTCCAGACACAATAAGGATTGACAGATTGAGAGCTTCTTTCTTGATTTTGTGGGTGGTGGTGCATGGCCGTTCTTAGTTGGTGGGATGACTTGTCTGCTTAATTGCGATAACGAACGAGACCTTTAACCTACTAAATAGCCAGGCTAGCTTTGGCTGGTCGCCGGCTTCTTAGAGGGACTATCGGCTCAAGCCGATGGAAGTTTGAGGCAATAACAGGTTAACTTCACAGGCCTGTAACAGCAGGCCTCAGACTTTCCGGTGGGGTGTTGGATACACTGCTAGTACACCATCTTAATCGCTGTGGGACGAGTGTCCCTATTATGAGGCAGCGACCGCTCGAGGTGATGGGTGCGAGACAACCTGGTACAGGGGACGCCGGCAGCTTTTCTGCCGGCCAATCCTGTGGCGAGATGGAGTAACGCCCATCCGTCGCAACGCACGCTAAGGTGTCGGTCTGCTGGAGCTTCTTCAGAAGCTTCGGTAGGCTTAAGGTTCGTGCTAGCCCCCGCGTAAGCGGGCCCCGAGAAATAGGTCTCATAAGCCAAAGTCTCGGGGGGTTGCAGAGGGGGGAGGAGAGGCCTGAACCAGACCTCGCTCCTCTGCGNNGGGGGGGGGTTTTGCTCTGCGCCTGCCGCAAAGCAAACCCACATCTGCTNTGATGCCCTTAGATGTTCTGGGCCGCACGCGCGCTACACTGACAGAGCCAACGAGTTCATCACCTTGGCCGAAAGGCCTGGGTAATCTTGTTAAACTCTGTCGTGCTGGGGATAGAGCATTGCAATTATTGCTCTTCAACGAGGAATTCCTAGTAAGCGCAAGTCATCAGCTTGCGTTGAATACGTCCCTGCCCTTTGTACACACCGCCCGTCGCTACTACCGATTGAATGGCTCAGTGAGGCTTTCGGACTGGCCTAGGAAGAGTGGCAACACTCATCCAGGGCCAGAAANTNCCCAAA >UAMH03101_UAMH_SSU CATGTCTAAGTATAAGCAATCTATACTGTGAAACTGCGAATGGCTCATTAAATCAGTTATCGTTTATTTGATAGTACCTTACTACTTGGATAACCGTGGTAATTCTAGAGCTAATACATGCTAAAAACCTCGACTTCGGAAGGGGTGTATTTATTAGATAAAAAACCAATGCCCTTCGGGGCTCCTTGGTGATTCATAATAACTTAACGAATCGCATGGCCTTGTGCCGGCGATGGTTCATTCAAATTTCTGCCCTATCAACTTTCGATGGTAGGATAGTGGCCTACCATGGTTTCAACGGGTAACGGGGAATTAGGGTTCTATTCCGGAGAGCGAGCCTGAGACACGGCTAGCACATCCAAGGAAGGCAGCAGGCGCGCAAATTACCCAATCCCGACACGGGGAGGTAGTGACAATAAATACTGATACAGGACTCTTTTGGGTCTTGTAATTGGAATGAGTACAATTTAAATCCCTTAACGAGGAACAATTGGAGGGCAAGTCTGGTGCCAGCAGCCGCGGTAATTCCAGCTCCAATAGCGTATATTAAAGTTGTTGCAGTTAAAAAGCTCGTAGTTGAACCTTGGGCCTGGCTGGCCGGTCCGCCTCACCGCGTGCACTGGTCCGGCCGGGCCTTTCCTTCTGGGGAGCCGCATGCCCTTCACTGGGTGTGTCGGGGAACCAGGACTTTTACTTTGAAAAAATTAGAGTGTTCAAAGCAGGCCTATGCTCGAATACATTAGCATGGAATAATAGAATAGGACGTGTGGTTCTATTTTGTTGGTTTCTAGGACCGCCGTAATGATCAATAGGGATAGTCGGGGGCATCAGTATTCAATTGTCAGAGGTGAAATTCTTGGATTTATTGAAGACTAACTACTGCGAAAGCATTTGCCAAGGATGTTTTCATTAATCAGTGAACGAAAGTTAGGGGATCGAAGACGATCAGATACCGTCGTAGTCTTAACCATAAACTATGCCGACTAGGGATCGGGCGATGTTACTTTTTTGACTCGCTCGGCACCTTACGAGAAATCAAAGTCTTTGGGTTCTGGGGGGAGTATGGTCGCAAGGCTGAAACTTAAAGAAATTGACGGAAGGGCACCACAATGGAGTGGAGCCTGCGGCTTAATTTGACTCAACACGGGGAAACTCACCAGGTCCAGACACAATAAGGATTGACAGATTGAGAGCTCTTTCTTGATTTTGTGGGTGGTGGTGCATGGCCGTTCTTAGTTGGTGGGATGACTTGTCTGCTTAATTGCGATAACGAACGAGACCTTAACCTACTAAATAGCCAGGCTAGCTTTGGCTGGTCGCCGGCTTCTTAGAGGGACTATCGGCTCAAGCCGATGGAAGTTTGAGGCAATAACAGGTTAACTTCACAGGCCTGTAACAGCAGGCCTCAGACTTTCCGGTGGGGTGTTGGATACACTGCTAGTACACCATCTTAATCGCTGTGGGACGAGTGTCCCTATTATGAGGCAGCGACCGCTCGAGGTGATGGGTGCGAGACAACCTGGTACAGGGGACGCCGGCAGCTTTTCTGCCGGCCAATCCTGTGGCGAGATGGAGTAACGCCCATCCGTCGCAACGCACGCTAAGGTGTCGGTCTGCTGGAGCTTCTTCAGAAGCTTCGGTAGGCTTAAGGTTCGTGCTAGCCCCCGCGTAAGCGGGCCCCGAGAAATAGGTCTCATAAGCCAAAGTCTCGGGGGGTTGCAGAGGGGGGAGGAGAGGCCTGAACCAGACCTCGCTCCTCTGCGCTGGGGGGGGGTTTTGCTCTGCGCCTGCCGCAAAGCAAACCCCATCTGCTGTGATGCCCTTAGATGTTCTGGGCCGCACGCGCGCTACACTGACAGAGCCAACGAGTTCATCACCTTGGCCGAAAGGCCTGGGTAATCTTGTTAAACTCTGTCGTGCTGGGGATAGAGCATTGCAATTATTGCTCTTCAACGAGGAATTCCTAGTAAGCGCAAGTCATCAGCTTGCGTTGAATACGTCCCTGCCCTTTGTACACACCGCCCGTCGCTACTACCGATTGAATGGCTCAGTGAGGCTTTCGGACTGGCCTAGGAAGAGTGGCAACACTCATCCAGGGCCGGAAAGTTGTCCAAACTNGGTC >UAMH03101_GQ272628_SSU-LSU AGGGATCATTACAGAGTTCCTGCCCTCACGGGTAGATCTCCCACCCTTGTGTATTTTTATGATGTCTTGTTGCTTTGGCAGGCCGCTGGGCTTCTTCGGCCTGGCCACCGGCTCCCTGGGGGCTGGTGCGCGCCTGCCAGAGGATCTCTCAAACTCGGTTTGTTAGTGTCGTCTGAGTACTATAACAATCGTTAAAACTTTCAACAACGGATCTCTTGGTTCTGGCATCGATGAAGAACGCAGCGAAATGCGATAAGTAATGTGAATTGCAGAATTCAGTGAATCATCGAATCTTTGAACGCACATTGCGCCCCTTGGTATTCCGAGGGGCATGCCTGTTCGAGCGTCATTTCAACCCCTCAAGCTCTGCTTGGTGTTGGGCATTCGCCGCTTTCCCGCGGCGGGCCTTAAAATCAGTGGCGGTGGCCGTCTTAGGCTCTAAGCGTAGTAGTAACCTCTCGCTCTGGAGACCCGGCGGTGACCTGCCAGACAACCTTTTTTACTTTTTTTCAAAGGTTNGACCTCGGATCAGGTAGGGATACCCGCTGAAT |
IMAGES: